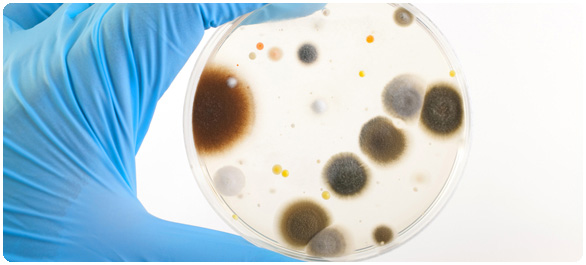
โรคจากเครื่องปรับอากาศ โรคจากเครื่องปรับอากาศ

on
โรคจากเครื่องปรับอากาศ (ตอนที่ 2)
2 สิงหาคม 2014
คนส่วนใหญ่ติดเชื้อได้จากการหายใจเอาละอองน้ำขนาดเล็ก (Microscopic water droplets) ที่มีเชื้อลีจิโอเนลลา ทั้งนี้การแพร่กระจายของโรคอาจมาจากแหล่งดังต่อไปนี้
- ฝักบัว ก๊อกน้ำ ท่อน้ำร้อนและอ่างน้ำวน (Whirlpool)
- หอหล่อเย็น (Cooling towers) ของระบบปรับอากาศ
- น้ำพุที่ใช้ตกแต่งเพื่อความสวยงาม (Decorative fountains)
- สระว่ายน้ำ
- ระบบน้ำในโรงแรม โรงพยาบาล และสถานดูแลผู้ป่วย
- ระบบระบายอากาศ (Ventilation system) ในอาคารใหญ่
- การสูดสำลักเข้าปอด (Aspiration) ซึ่งมักเกิดตอนที่กำลังดื่มแล้วมีอาการไอหรือสำลักเอาน้ำที่มีเชื้อเข้าไป
ไม่ใช่ทุกคนที่ได้รับเชื้อลีจิโอเนลลาจะต้องป่วย อาการป่วยโดยมากมักเกิดกับผู้สูงอายุหรือวัยกลางคน แต่ไม่ค่อยพบในเด็ก ทั้งนี้ โดยมีปัจจัยเสี่ยง ได้แก่
- การดื่มแอลกอฮอล์ (Alcohol abuse)
- การสูบบุหรี่
- ป่วยเรื้อรัง เช่น โรคไตวาย หรือ โรคเบาหวาน
- มีระบบภูมิคุ้มกันต่ำ เช่น อยู่ระหว่างรับการรักษาโรคมะเร็ง กินยาสเตียรอยด์ หรือเป็นโรคเอดส์
- เป็นโรคปอดเรื้อรัง เช่น โรคซีโอพีดี (Chronic obstructive pulmonary disease = COPD)
- มีการใช้เครื่องช่วยหายใจ (Ventilator) เป็นระยะเวลานาน
- มีการใช้ยาที่กดภูมิคุ้มกัน เช่น เคมีบำบัด และ สเตียรอยด์
- ผู้สูงอายุ
ระยะการฟักตัวของโรคอยู่ระหว่าง 2-10 วัน นับจากได้รับเชื้อ อาการจะแย่ลงระหว่าง 4 – 6 วันแรก และส่วนใหญ่จะค่อยๆ ดีขึ้นในอีก 4 – 5 วันถัดมา อาการที่อาจเกิดขึ้น ได้แก่
- เจ็บหน้าอก
- ไอแห้ง
- ไอเป็นเลือด (Coughing up blood)
- ท้องเสีย คลื่นไส้ อาเจียน และปวดท้อง
- เป็นไข้
- รู้สึกไม่สบาย (Malaise)
- ปวดศีรษะ
- ปวดข้อ
- ไม่มีแรง
- ปวดเมื่อยกล้ามเนื้อ
- มีปัญหาเรื่องการทรงตัว
- หนาวสั่น
- หายใจลำบาก (Shortness of breath)
แหล่งข้อมูล
1. Legionnaires' disease. [2014, August 1].
2. Legionnaire disease. [2014, August 1].